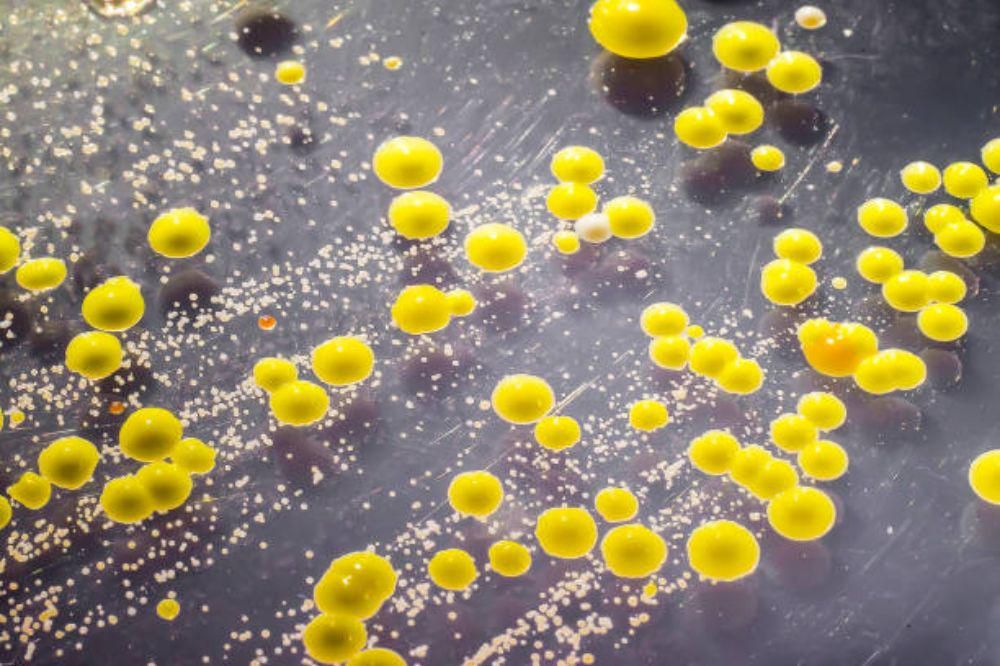
7 penyebab pembengkakan kelenjar getah bening di ketiak, cek sekarang!

Berita Kategori "Kesehatan "
Dokter, apa saja pemeriksaan yang diperlukan sebelum inseminasi buatan?
Pemeriksaan yang Perlu Dilakukan Sebelum Program Hamil Inseminasi Buatan Jika Anda sedang merencanakan untuk menjalani program hamil inseminasi buatan atau IUI, penting untuk memahami pemeriksaan-pemeriksaan yang
11 Tanda Orang Sedang Berjuang Sendirian Meski Terlihat Bahagia
Tanda-Tanda Kesepian yang Tidak Terlihat dari Luar Apakah Anda pernah melihat rekan kerja yang selalu tersenyum, tetangga yang ramah setiap pagi, atau teman yang hampir tak pernah absen dari acara sosial? Di balik
Delapan Minuman Elektrolit untuk Hidrasi, Termasuk Air Kelapa
Pentingnya Hidrasi Tubuh dan Minuman Kaya Elektrolit Kecukupan cairan tubuh atau hidrasi sangat penting untuk menjaga kesehatan dan memastikan aktivitas sehari-hari berjalan dengan lancar. Namun, ketika tubuh mengalami
7 penyebab pembengkakan kelenjar getah bening di ketiak, cek sekarang!
Penyebab Pembengkakan Kelenjar Getah Bening di Ketiak Pernah merasa ada benjolan di ketiak atau kelenjar getah bening terasa membesar? Jangan panik dulu. Pembesaran kelenjar getah bening, atau limfadenopati, adalah
Hexa Reef ubah Pantai Tlangoh: Dari abrasi jadi destinasi wisata pesisir
Perubahan di Dasar Laut yang Mengubah Nasib Warga Tlangoh Di Pantai Tlangoh, Kabupaten Bangkalan, Jawa Timur, perubahan tidak datang dari gedung tinggi atau investasi besar, melainkan dari dasar laut. Struktur hexa reef
7 Manfaat Psikologis Membuat Resolusi Tahun Baru, Tingkatkan Rasa Percaya Diri
Manfaat Psikologis Membuat Resolusi Tahun Baru Membuat resolusi tahun baru bukan hanya sekadar menetapkan tujuan, tetapi juga memiliki dampak psikologis yang signifikan terhadap diri kita. Ini menjadi cara untuk
Libur Nataru, Anak Rentan Flu: Dokter Jelaskan Bahaya dan Pencegahan
Meningkatnya Risiko Flu pada Anak Saat Libur Nataru Perubahan cuaca yang terjadi selama masa libur Natal dan Tahun Baru (Nataru) dapat meningkatkan risiko anak terserang flu. Hal ini disebabkan oleh penurunan daya tahan
ADHD, Disleksia, dan Luka yang Tak Pernah Sembuh
Perjalanan Menemukan Diri yang Tidak Terlalu Sempurna Saya lama percaya bahwa hidup saya akan baik-baik saja jika pikiran ini bisa ditertibkan. Sebagai penyandang disleksia dan ADHD, saya tumbuh dalam dunia yang terus
Goodvibes x Atelier Riri Luncurkan Parfum dengan Aroma Unik dan Makna Mendalam
Kolaborasi Kreatif antara GoodVibes dan Atelier Riri GoodVibes, brand aromaterapi dan wellness asal Indonesia, resmi meluncurkan parfum terbarunya yang diberi nama SOLEMN Eau De Perfume. Peluncuran ini dilakukan secara
Dokkes Polres Aceh Singkil Bantu Kesehatan Petugas Pengamanan Nataru
Persiapan Kesehatan untuk Petugas Pengamanan Nataru 2025-2026 Tim Dokkes Polres Aceh Singkil melakukan berbagai langkah khusus untuk memastikan kesehatan personel yang akan bertugas dalam pengamanan perayaan Natal dan